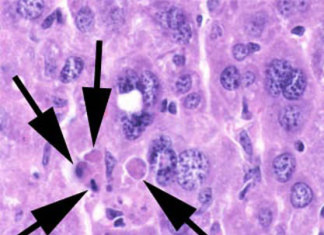
Marcado para la destrucción: Nuevo desarrollo desencadena la muerte de las células cancerosas

Investigadores identifican células del cerebro clave en la acción antidepresiva
Los medicamentos antidepresivos como el Prozac ha ayudado a mejorar el estado de ánimo y disminuir la ansiedad en millones de personas con depresión....
Brentuximab Vedotin: eficaz en linfoma de células grandes
Más de la mitad de los pacientes con recaída o linfoma células grandes (LACG) tratados con el anticuerpo CD30 y con los fármacos dirigidos...
Te gusta el curry? Nueva función biológica identificada para el compuesto...
Los científicos han identificado una nueva razón por qué algunos platos de curry, han sido utilizados por los seres humanos durante miles de años.
Una...
Tioridazina mata a las células madre del cáncer en humanos, evitando...
Un equipo de científicos de la Universidad McMaster ha descubierto una droga, la tioridazina, con éxito mata a las células madre del cáncer en...
Marcado para la destrucción: Nuevo desarrollo desencadena la muerte de las...
La familia de las proteinas BCL-2 juegan un papel importante en determinar si las células cancerosas sobreviven en la respuesta al tratamiento o siguen...
Nueva prueba muestra potencial para detectar casos activos de la enfermedad...
Ya se puede saber si una picadura de garrapata significa la presencia de la enfermedad de Lyme y antes de que la víctima de...
Desarrollo de nuevos fármacos para tratar la diabetes
Los informes de la Asociación Canadiense de Diabetes informan que nueve millones de canadienses viven con diabetes o prediabetes y que 20 nuevos casos...
Sentir emociones fuertes hace «sincronizar» los cerebros
Experimentar emociones fuertes sincroniza la actividad del cerebro entre los individuos, el equipo de investigación en la Universidad de Aalto y Turku en Finlandia...
Abbott lanza FreeStyle InsuLinx en Barcelona
Abbott presenta un nuevo sistema de control de glucosa en sangre denominado ‘FreeStyle InsuLinx’, en el marco de una reunión de expertos celebrada en...
Los dispositivos intrauterinos, DIU, implantes anticonceptivos más eficaces
Un estudio para evaluar los métodos de control de la natalidad ha encontrado grandes diferencias en su eficacia. Las mujeres que utilizan píldoras anticonceptivas,...
La aspirina puede prevenir la recurrencia de coágulos sanguíneos en las...
Después de sufrir un tipo de coágulo de sangre llamado tromboembolismo venoso, los pacientes suelen tomar un anticoagulante como la warfarina (Coumadin). Sin embargo,...
Suplementos de calcio relacionados con un riesgo de ataque al corazón
Los suplementos de calcio pueden aumentar el riesgo de sufrir un ataque al corazón, y se deben "tomar con precaución", concluye la investigación publicada...